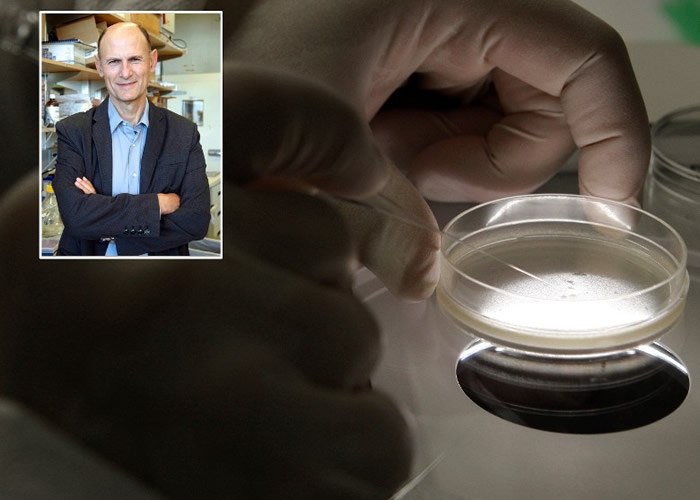

美西科学家在中国成功培殖出一个人猴胚胎掀伦理争议
人猴胚胎实验由贝尔蒙特(小图)主持。科学
(神秘的家中地球uux.cn报道)据东网:西班牙《国家报》周三(7月31日)报道,该国与美国科学家团队早前在中国成功培殖出一个人猴胚胎。国成功培个人但团体为了避免引起伦理争议,殖出争议决定在胚胎2周大时终止计划,猴胚并销毁胚胎。胎掀
研究团队以59岁西班牙科学家贝尔蒙特(Juan Carlos Izpisua Belmonte)为首,伦理成员分别来自西班牙穆尔西亚天主教大学、美西美国加州索尔克生物研究所。科学为免引起法律问题,家中团队选择在中国试验,国成功培个人研究员把人类干细胞植入猴子的殖出争议胚胎中,最终胚胎长出各类人体组织。猴胚但在长出中央神经系统前中止实验,胎掀研究人员把胚胎销毁。
曾于前年成功培殖人猪胚胎的贝尔蒙特称,成形后的干细胞可应用在人类器官移植。不过,巴塞隆拿再生医学中心主任拉亚(Angel Raya)质疑,倘胚胎大脑发展出人类神经元,有可能产生自我意识,引起伦理争议。参与研究的努涅斯(Estrella Nunez)也承认,当人类干细胞植入胚胎大脑,可能会产生自我毁灭的意识。
本文地址:http://ey.qingse-two.com/news/187a318396629.html
版权声明
本文仅代表作者观点,不代表本站立场。
本文系作者授权发表,未经许可,不得转载。